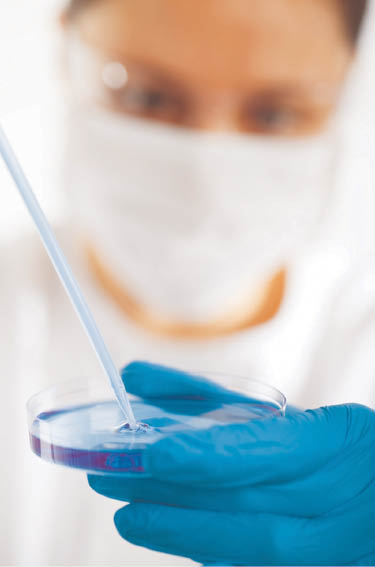

Snapshots
News from the clinics
Increased incidence of cancer of the female external genitalia: New guidelines for vulva cancer published
Berlin, March 2016: In 2015 more than 4000 women were diagnosed with vulva cancer. The number of cases of cancer of the female external genitalia has risen dramatically in the last few years. This was one of the reasons why the German Society of Gynecology and Obstetrics e.V. (DGGG) and the German Cancer Society e.V. (DKG), revised its guidelines, which have now been published in a new form.
The external genitalia of the woman consist of the large and small labia, the clitoris, the vaginal opening and the urinary meatus. Cancers in this area were rare until recently, occurring mostly in post-menopausal women. However, over the last few years there has been an increase in vulvar cancer in younger women and it is, like cancer of the cervix (cervical cancer), frequently a result of infection with human papillomaviruses (HPV). “The disease rates have doubled in the past decade, and soon there will be more cases of vulvar cancer than cervical cancer”, says Prof. Dr. Hans-Georg Schnürch, Neuss, Germany.
Nevertheless, vulvar cancer was in the shadow of cervical cancer for a long time. “In many areas of diagnosis, treatment and follow-up, there were a number of unresolved issues that have made it necessary to review the guidelines last published in 2009”. An interdisciplinary commission of experts [Organ Commission Vulva/Vagina of the Working Group on Gynecological Oncology e.V. (AGO)] coordinated by Prof. Dr. Monika Hampl and Prof. Dr. Hans-Georg Schnürch has therefore met several times over the last few months and in a structured process of consensus adopted a total of 68 recommendations and nine statements (source: AGO).
According to these recommendations, high-risk squamous intraepithelial lesions (HSIL) and vulvar intraepithelial neoplasia (dVIN) lesions should be removed in sano by excision, histologically or by laser vaporization, according to the clinical assessment (Source: AWMF online).
The guidelines can be found at:
http://www.awmf.org/leitlinien/detail/ll/015-059.html
(09.05.2016)
Funding
EUREKA network
EUREKA is a Europe-wide network for industrial research and development, strengthening European competitiveness by promoting “market-driven” collaborative research and development (R&D) projects. It contains of 41 full members, including the European Union. Additionally, several European countries such as Albania and Bosnia and Herzegovina can participate in EUREKA cooperation through a network of so-called national information points (NIPs). EUREKA also enhances cooperation with countries outside of Europe which have been judged to have scientific and research potential, such as Canada, Republic of Korea and South Africa. EUREKA follows a “bottom-up” approach which allows the project consortia to define the nature of the technologies to be developed and how the project comes together.

Flag of the European Union (© Richard Revel @ PublicDomainPictures.net).
In doing so, EUREKA provides two types of services:
Administrative support (e.g. partner search and help to reach cooperation agreements, technology transfer and intellectual property rights, help in formulating project ideas)
Facilitating access to financial support (venture capital and loans, public financial aid, tax credits).
To set up a EUREKA project there must be at least two partners from two different EUREKA countries. Partners can be of any type: small and medium-sized enterprises (SMEs), large companies, research institutions and universities (Source: EUREKA).
Detailed funding details can be found at:
(02.05.2016)
Bayern strengthens cluster activity in medical technology
The successful work of the Forum MedTech Pharma e.V. (FMP) and the Medical Valley EMN e.V. (MVEMN), whose common goal is to increase the innovativeness of the Bavarian medical technology industry, particularly for SMEs, has been acknowledged and further support has been granted. The Bavarian Ministry of Economic Affairs and Media, Energy and Technology approved a total of €900,000 for the network offers of FMP and MVEMN within the cluster promotion “Medical technology” of 2019.
Both organizations, who cooperate closely, aim to further extend their services which provide support for outstanding biomedical ideas from development through to commercial implementation.
In the next few years, the aim is to create high-profile research and development projects and to provide support during implementation. For this, inter alia, successful event formats such as the Congress MedTech Summit are to be expanded, expert panels in application fields such as medical robotics to be initiated, open innovation and ideas competitions to be held and companies support in funding acquisition to be given (Source: City of Erlangen).
Please also visit:
http://www.cluster-medizintechnik.de/
(02.05.2016)
Awards
Jürgen Popp awarded AIMBE Fellowship
The prestigious American Institute for Medical and Biological Engineering (AIMBE) has elected Prof. Jürgen Popp, Scientific Director of the Leibniz Institute of Photonic Technology (IPHT) and Director of the Institute of Physical Chemistry of the Friedrich-Schiller University of Jena, to its College of Fellows. Jürgen Popp was selected for his outstanding contributions to the development and clinical application of Raman spectroscopy in infection diagnostics. The celebration ceremony took place on April 4, 2016 in Washington DC, USA.

Raman set-up (Source: LMTB Berlin).
The AIMBE Fellowship is bestowed on researchers who have made a significant and lasting contribution in the field of medical technology. Only a few of the elected members are from countries outside the USA.
Prof. Popp studied Chemistry at the University of Erlangen and Würzburg. Since 2002 he has been Director of the Institute of Physical Chemistry of the Friedrich-Schiller University of Jena. In 2006 he was additionally appointed as Scientific Director of IPHT. He is the author of more than 540 publications, holds 12 patents related to spectroscopic instrumentation and is Editor-in-Chief of the Journal of Biophotonics. In 2012 he was awarded an honorary doctorate from the University of Cluj-Napoca (Romania), and in 2013 he was awarded the Robert Kellner Lecture Award.
Furthermore, for his substantial contribution to the field of applied spectroscopy, he was awarded the Pittsburgh Spectroscopy Award 2016 (Source: Britta Opfer, Press and Public Relations, IPHT).
The complete press release can be found at:
(09.05.2016)
Personal news
Rolf Heuer is the new president of the German Physical Society (DPG)
Berlin/Bad Honnef, March 30, 2016. On April 5, 2016 Rolf Heuer took over the presidency of the German Physical Society (DPG). He succeeds Edward G. Krubasik who was President from April 2014 to April 2016 and who will now become vice president. The DPG is the largest physical society in the world, boasting more than 62,000 members.
During his presidency, Heuer has expressed his wish to devote particular attention to the young. “Children are naturally curious. We want to inspire them with enthusiasm for science and technology. Motivating lessons by inspiring teachers is the key to an interest that can last a lifetime”, the new DPG president says.
Heuer, born in 1948, was Director General of the European Particle Accelerator Center (CERN) near Geneva from January 2009 to December 2015. During his tenure, the long-sought Higgs particle was discovered by the proton collision machine called the Large Hadron Collider (LHC), which confers mass to elementary particles, and completes the so-called standard model of particle physics. As a result of this discovery, François Englert and Peter Higgs were awarded the Nobel Prize for Physics in 2013.
Heuer studied Physics at the University of Stuttgart and obtained his doctorate from the University of Heidelberg in 1977. Between 1977 and 1983 Heuer worked on the DORIS and PETRA colliders at the German Electron Synchrotron (DESY) in Hamburg. In 1984 he moved from Heidelberg to CERN, where he worked for the OPAL collaboration – one of the four major experiments on the Large Electron-Positron Collider (LEP). From 1994 to 1998 he headed the collaboration with more than 300 scientists.
In 1998, Heuer was appointed a C4 professor at the University of Hamburg. During this time he established, at DESY, one of the world’s leading groups for experiments on future electron-positron colliders. From December 2004 to December 2008 Heuer was Director of Research of Particle Physics and Astroparticle Physics at DESY. He played a decisive part in establishing the Hamburg accelerator center as the central laboratory for particle physics in Germany, and reinforced collaboration with universities and CERN. He also played a leading role in the restructuring and focusing of particle physics research at the highest energy levels in Germany, with particular emphasis on the LHC, which was commissioned at CERN in 2009 under his leadership (Source: DPG).
The complete press release and pictures of the handover ceremony can be found at:
https://www.dpg-physik.de/presse/pressemit/2016/dpg-pm-2016-07.html
(09.05.2016)
Broader view
3D print in medicine
Medical applications for 3D printing are expanding rapidly and are expected to revolutionize health care. It is conceivable, for example, to fabricate biological tissues and organs, to create customized prosthetics, implants, and anatomical models and to speed up pharmaceutical research regarding drug dosage forms, delivery, and discovery. The application of 3D printing in medicine promises many advantages such as the customization and personalization of medical products, drugs, and equipment, a better cost-effectiveness, an increased productivity, the democratization of design and manufacturing, and last but not least, an enhanced interdisciplinary collaboration.
Starting with a virtual design using a 3D modeling program to prepare a digital file for printing, any object can be created layer by layer. The way layers are built to create the final object can be different. One can use melted or softened material to produce the layers (e.g. by selective laser sintering and fused deposition modeling), or a photo-reactive resin which is cured with a ultraviolet laser or another similar power source one layer at a time (e.g. by stereolithography).
The latest news about 3D printing in medicine can be found at:
http://www.3dmake.de/thema/3d-druck-in-der-medizin/
(09.05.2016)
Novel cancer treatment developed to inhibit chemo-resistance
Many patients develop resistance to standard therapies and eventually relapse. Now researchers hope to improve treatment outcomes with the development of a novel therapeutic strategy, called adaptive therapy, which is based on evolutionary principles and aims to keep resistant cells in check by maintaining a population of chemo-sensitive cells.
Typically cancer drugs are given at the maximum tolerated dose that a patient can tolerate without any life-threatening toxicity. While chemo-sensitive cells are removed, existing chemo-resistant cells can survive and then continue to grow and divide despite the ongoing therapy.
Researcher using a Petri dish (© Petr Kratochvil @ PublicDomainPictures.net).
Recently, researchers at the Moffitt Cancer Center & Research Institute developed a novel treatment strategy based on evolutionary principles and originally tested by mathematical models. Rather than reducing tumor size with a maximum tolerated dose and leaving only resistant cells, the researchers’ goal was to prolong survival without disease progression. This strategy, termed an adaptive strategy, uses short bursts of therapy to maintain a residual population of chemo-sensitive cells that keep resistant cells in check and prevent them from growing uncontrollably. The new approach was investigated and found to be effective in preclinical mouse models of triple-negative and ER+ breast cancer and published in the Science Translational Medicine journal. The researchers treated mice with the common breast cancer chemotherapeutic agent paclitaxel according to three different treatment strategies: (1) the standard maximum dose (ST), (2) an adaptive therapeutic dose (AT-1) in which the frequency of paclitaxel is the same but the dose decreases as the tumor responds, and (3) a second adaptive therapeutic dose (AT-2) in which the dose of paclitaxel is the same but doses are skipped when the tumor responds to therapy. As a result all three treatment strategies initially decreased tumor growth to similar levels, but as soon as the tumors responded and treatment stopped during the standard regimen or was skipped during the AT-2 regimen, the tumors rapidly regrew. Finally, mice treated with the AT-1 regimen survived significantly longer than the mice in the standard and AT-2 treatment groups. Based on these promising preclinical results, the Moffitt researchers, led by Jingsong Zhang, MD, PhD, assistant member of the Genitourinary Oncology Program, have initiated the first clinical trial assessing the efficacy of an adaptive treatment strategy in prostate cancer patients (Source: ScienceDaily).
More detailed information on this topic can be found at:
https://www.sciencedaily.com/releases/2016/02/160224164357.htm
(09.05.2016)
See also the original article: Enriquez-Navas PM, Kam Y, Das T, Hassan S, Silva A, Foroutan P, Ruiz E, Martinez G, Minton S, Gillies RJ, Gatenby RA. Exploiting evolutionary principles to prolong tumor control in preclinical models of breast cancer. Sci Transl Med 2016;8(327):327ra24.
©2016 Walter de Gruyter GmbH, Berlin/Boston
Articles in the same Issue
- Frontmatter
- Editorial
- Light and lasers for vascular and skin diseases: From bench to clinic – An update
- Magazine section
- Snapshots
- Original contributions
- A study on the effects of 532 nm continuous laser combined with photodynamic therapy versus 595 nm pulsed dye laser on a chicken comb model of vascular malformation
- Calibration of a three-dimensional photodynamic therapy illumination system and its segmentation assessment for port-wine stains
- In-vitro effect of antimicrobial photodynamic therapy with methylene blue in two different genera of dermatophyte fungi
- Low-level laser therapy enhances muscle regeneration through modulation of inflammatory markers
- Case reports
- Treatment of recalcitrant viral warts using a 577-nm wavelength high-power optically pumped semiconductor laser
- Can laser therapy be the answer for radiodermatitis in anal cancer patients? Two case reports
- Use of a 1318 nm Nd:YAG laser for the resection of limited forms of pulmonary tuberculosis
- Congress announcements
- Congresses 2016/2017
Articles in the same Issue
- Frontmatter
- Editorial
- Light and lasers for vascular and skin diseases: From bench to clinic – An update
- Magazine section
- Snapshots
- Original contributions
- A study on the effects of 532 nm continuous laser combined with photodynamic therapy versus 595 nm pulsed dye laser on a chicken comb model of vascular malformation
- Calibration of a three-dimensional photodynamic therapy illumination system and its segmentation assessment for port-wine stains
- In-vitro effect of antimicrobial photodynamic therapy with methylene blue in two different genera of dermatophyte fungi
- Low-level laser therapy enhances muscle regeneration through modulation of inflammatory markers
- Case reports
- Treatment of recalcitrant viral warts using a 577-nm wavelength high-power optically pumped semiconductor laser
- Can laser therapy be the answer for radiodermatitis in anal cancer patients? Two case reports
- Use of a 1318 nm Nd:YAG laser for the resection of limited forms of pulmonary tuberculosis
- Congress announcements
- Congresses 2016/2017